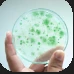
Cyanobacteria.PNG Cyanobacteria.PNG

※ゲーム環境によって名称や説明文に表記ブレあり。
ここではSteam版を基準に記載しています。
”文明” 一覧
”テクノロジー” 効果別一覧
”テクノロジー” (「研究」タブから購入する)は各文明の「アイデア」出力ブーストと次文明のアンロック条件。効率の良いものから積極的に取っていきたい。
石器時代
新石器時代
青銅器時代
鉄器時代
中世
大航海時代
| 名称 | 効果 | ロック解除条件 | 必要アイデア数 | 備考 | |
| -英 | 説明文/注釈 | ||||
![]() | キャラベル船 | 大航海時代 ×1.25 効率的 | 大航海時代 | 4.00 Qa | |
| -Caravel | 小型で高速な帆船で、15~16世紀の海洋探査を可能にしました。 | ||||
![]() | アストロラーベ | 大航海時代 ×1.4 効率的 | 大航海時代 | 8.00 Qa | |
| -Astrolabe | 天体やナビゲーターが天体の位置を計算するために使用するツール。文字通り、「天体を捉える者」と解釈されます。 天文学者や航海士が天体の位置を計算するのに使用する道具。名前は「天体を捉える者」という意味である。 ※アストロラーベ(Astrolabe、アラビア語でaṣṭurlāb)は「星を掴む者」の意味がある) | ||||
![]() | ガレオン船 | 大航海時代 ×1.25 効率的 | キャラベル船 | 16.00 Qa | |
| -Galleon | 武装した貨物船や軍艦として使用される大型の帆船。海上商戦と海軍戦争の柱である。 武装商船や軍艦として使用される大型の帆船。海商および海戦の主役である。 | ||||
![]() | 方位磁針 | 大航海時代 ×1.75 効率的 | アストロラーベ | 32.00 Qa | |
| -Magnetic Compass | 磁石を使って針を常に北に向ける器具。あなたが世界のどこにいても、コンパスでどの方向に向かっているのかを常に把握することができます。 | ||||
![]() | 国際貿易 | 大航海時代 ×2 効率的 | キャラベル船 銀行業 | 64.00 Qa | |
| -Global Trade | 世界一周航海が可能になると、探検船に続いて商船がすぐに就航します。利益を求めて大陸間で商品を輸送する競争が始まります。好況と不況に揺さぶられながら、世界規模の貿易市場が形成され、世界経済が生まれていきます。 | ||||
| 六分儀 | 大航海時代 ×2.1 効率的 | アストロラーベ | 128.00 Qa | ||
| -Sextant | 2つの可視オブジェクト間の距離を測定するためのツール。天体ナビゲーションに使用されます。これとアストロラーベの間で、船員たちはより複雑なコースを描き、これまで以上に地球を探検することができました。 目視できる2つの物体の距離を測定するための道具。天測航行で使われる。この六分儀とアストロラーベを併用して船乗りはより精巧な海図を描き、それまで以上に地球を探索することが可能となった。 | ||||
![]() | 地動説 | 大航海時代 ×2.2 効率的 | 方位磁針 | 256.00 Qa | |
| -Heliocentrism | 16 世紀初頭、数学モデルによって、宇宙は地球の周りを回っているという根強い信念は打ち砕かれました。太陽を既知の宇宙の中心に置くことは大きな前進ですが、それはほんの始まりにすぎません。この理論は厳格に検証されるでしょう。 | ||||
![]() | 顕微鏡 | 大航海時代 ×2.3 効率的 | 眼鏡 大航海時代 | 512.00 Qa | |
| -Microscope | 1590年頃、初めて私たちの目だけでは認識できない微少な世界を見ることができるようになりました。筒の中に一つ以上の湾曲したレンズを持つ顕微鏡は、物体をより大きく見せ、細菌、原生動物、生きた酵母、血球などを明らかにしました。 初めて人間の目で見る以上に小さい物体や生物を見ることができるようになった。全く新しい小さな世界が我々の前に開かれる。 | ||||
![]() | マチュピチュ | 大航海時代 ×11000000000 効率的 | 大航海時代 | 24.30 Hvg | 研究レベル52以上 |
| -Machu Picchu | アマゾン流域とアンデス山脈の境に位置するマチュピチュは、土木工学の最高峰です。車輪や鉄を使わずに、インカ人は500年もの地震や地滑りに耐える石造りの建造物、段々畑、水道システムを設計しました。 | ||||
![]() | 鋼 | 大航海時代 ×2 効率的 | 大航海時代 ラパ・ヌイ | 500.00 Hvg | |
| -Steel | 製造するのに安価である高い引長強さを持つ合金、鋼は強くて丈夫で、都市を造ることと武器を作ることにおいて使われます 安価に製造でき、高い引っ張り強度を持つ合金。鋼は強く丈夫で都市の建造や武器の製作において使用される。 | ||||
| [添付] | 株式市場 | 大航海時代 ×3 効率的 | 銀行業 マチュピチュ | 1.00 Svg | |
![]() | 植民地主義 | 大航海時代 ×4 効率的 | ガレオン船 大航海時代 | 8.00 Svg | |
| -Colonalism | ある国がその規則を他の国または領土のそれに拡張することを決定するシステム | ||||
![]() | マスケット銃 | 大航海時代 ×5 効率的 | ファイアーランス 大航海時代 | 112.00 Svg | |
| -Musket | プロペラントに点火して排気を一方的に追い出すことで、船を上向きに発進させることができます。ロケット弾は包囲戦の際に最初は武器として使われました。 火薬に点火した爆風を一つの方向に逃すことで導管の前方に弾を発射することができる。この銃撃によって戦場の危険性は急激に高まった。 | ||||
![]() | 大砲 | 大航海時代 ×6 効率的 | カタパルト ファイアーランス | 2.24 Ovg | |
| -Cannon | 推進剤を使用して大きな発射体を発射する砲撃の一種。大砲は戦場を横断して大規模な破壊を取り除き、戦争の戦い方を変えることができました。 発射火薬を使い大きな発射体を射出する砲の一種である。砲弾は戦場のいたる所を大きく破壊して刈り取り、戦いの在り方を変えた。 | ||||
| [添付] | 経度 | 大航海時代 ×10 効率的 | 地動説 マチュピチュ | 1.86 Nvg | |
科学革命
産業革命
核時代
情報化時代
創発期
特異点
知性アンドロイド
火星の植民地化
ローバー
有人探査
火星居住区
火星工場
マーティンシティ
アイデアタップの利益増加
その他
コメント
- ゲームの和文中、あまりにも翻訳…という箇所は青字で補足文を加筆してみました。 -- 2020-11-10 (火) 20:14:41
- あまりにも翻訳→あまりにも翻訳が -- 2020-11-10 (火) 20:15:19